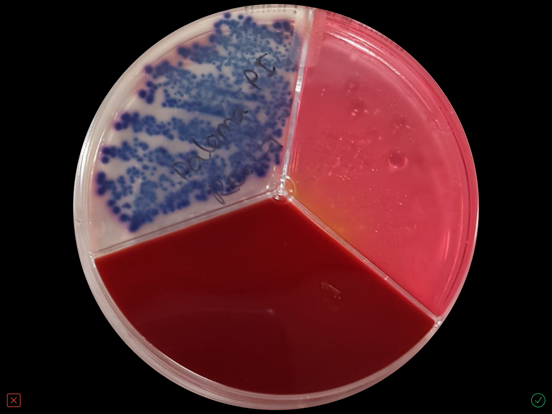
Screenshot #5 pour Vetorapid
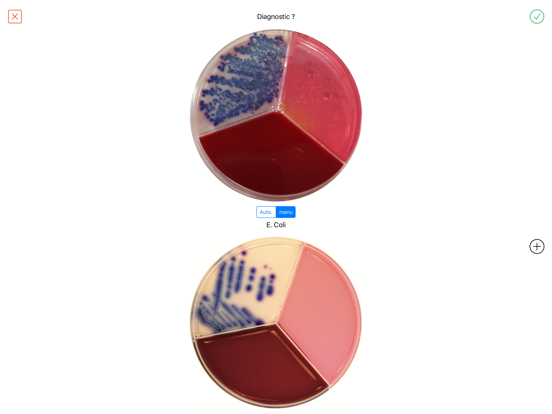
Screenshot #6 pour Vetorapid

Vetorapid
iOS Universel / Medecine
Using a picture of a VetoRapid plate, it helps you to confirm the pathogen(s) and establish a quick and adapted treatment.
VetoRapid app can use pictures taken by the user and pictures received in his smartphone through mail or any other messaging systems.
With VetoRapid app the dairy practitioner saves time and gains precision in prescribing the most adapted treatment, while contributing to build a valuable benchmark with each diagnostic.
VetoRapid app is available in most major European languages
To get an activation QR code please contact your Vetoquinol Territory Manager
En voir plus...
Quoi de neuf dans la dernière version ?
Fixed some minor UI problems